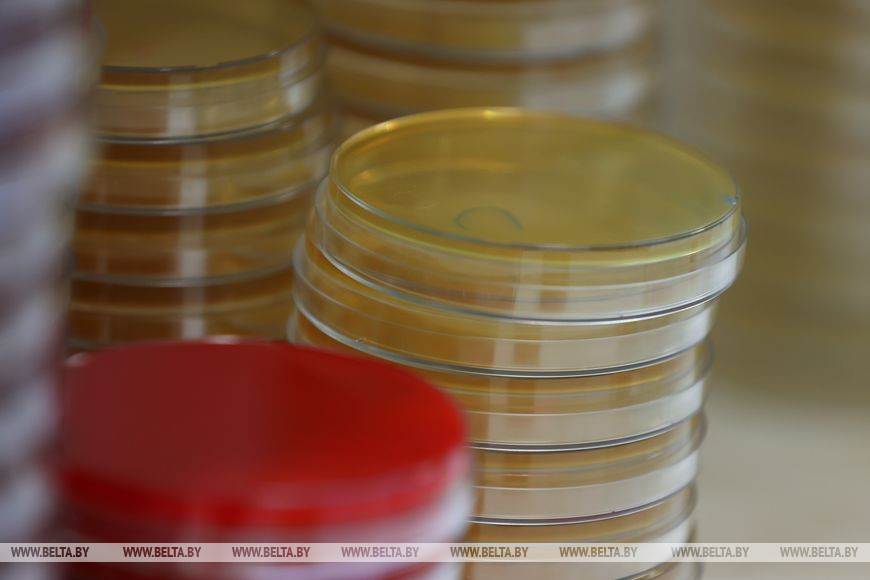

3 ноября, Минск /Корр. БЕЛТА/. Новый корпус детской инфекционной клинической больницы с уникальной лабораторией для нужд всего города открылся сегодня в Минске по ул.Якубовского, 53. Это событие стало подарком для жителей столицы в преддверии Дня Октябрьской революции, передает корреспондент БЕЛТА.

В здании, реконструкция которого велась в рамках комплексной модернизации клиники, разместились административные и служебные помещения, вирусно-бактериологическая лаборатория, особенно нужная и полезная в современных условиях распространения инфекционных заболеваний, в том числе COVID-19.
Лаборатория включает три блока - вирусологический, бактериологический и молекулярно-биологический, где в том числе проводятся исследования методом ПЦР. Сюда попадают анализы не только пациентов больницы и других пациентов детских стационаров, но и жителей всего Фрунзенского района и Минска в целом (особенно это актуально для оперативности проведения ПЦР-тестирования на ковид). Работает лаборатория круглосуточно: ночные дежурные занимаются анализами.

Как рассказала главный врач больницы Марина Соколова, новейшее оборудование позволило увеличить объемы исследований и оперативность их проведения, получения результатов. Здесь есть возможность комбинировать различные методы исследований к определению возбудителей болезней.
И.о. заведующего лабораторией Людмила Зельченко обратила внимание на уникальность нового комплекса, который построен по современным стандартам санитарно-эпидемиологических норм. В нем обеспечены безопасность труда работников, точность и скорость проводимых исследований на оборудовании экстра-класса.
Врач-бактериолог Алексей Лазарев добавил, что дооснащение оборудованием позволяет в полностью автоматической системе идентифицировать широкий спектр бактерий в течение одного дня. На двух аппаратах Vitek, например, единовременно идентифицируются до 90 культур из выделенных анализов.
А в отдельном блоке ПЦР-исследований с помощью этой точной и современной методики можно выявлять не только COVID-19, но и герпес, пневмококк и многие другие инфекции, а также определять наличие в крови антител. По словам врача-вирусолога Елены Ерчак, используется высокоскоростное оборудование - только на одном аппарате исследуется 96 проб одномоментно.
Комплексная реконструкция клиники ведется уже несколько лет. Большинство палатных корпусов уже были ранее обновлены, предполагается еще строительство одного нового. "За последние годы введены две реанимации, кабинеты КТ и МРТ, построен новый корпус, - отметила главврач. - Улучшены условия пребывания пациентов и работы персонала, обновилось оборудование. Дети и их мамы находятся в комфортных двухместных палатах (по два пациента с мамами) с отдельным санузлом".

При конечном фонде почти в 700 мест большинство из них сегодня заняты взрослыми пациентами с COVID-19. "Эта клиника оказывает помощь детям района, города, а в тяжелых случаях - со всей республики. В настоящее время в условиях пандемии в клинике перепрофилирована часть коек для оказания помощи взрослым с COVID-19. Таких сейчас две трети пациентов (из 600). А появление централизованной лаборатории позволяет проводить исследования не только для пациентов клиники, так и для других медучреждений как Фрунзенского района, так и всего Минска", - уточнил главный врач 2-й центральной районной поликлиники Фрунзенского района Николай Трубчик. Он добавил, что в районе в течение последних трех недель не наблюдается динамики роста заболеваемости COVID-19, и напомнил, что самым эффективным способом профилактики является вакцинация: в клиники попадают в основном непривитые пациенты (97-99%) и болеют довольно тяжело.-0-









Фото Андрея Покумейко
- размещаются материалы рекламно-информационного характера.